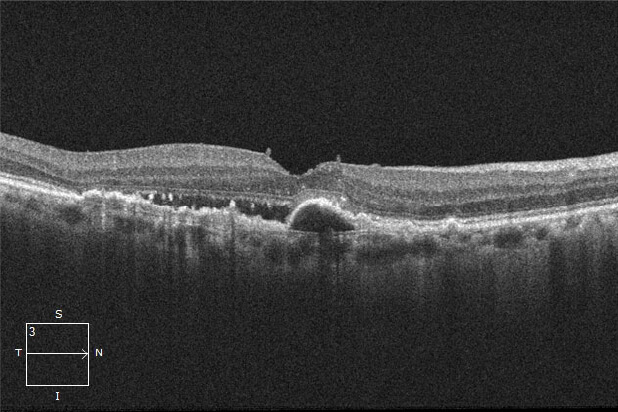
OCT検査による画像

目の病気について
加齢黄斑変性
加齢黄斑変性は、加齢により網膜の中心部である黄斑に障害が生じ、見ようとするところが見えにくくなる病気です。60歳以上の男性に多く発症し、喫煙歴や肥満、高脂肪食の摂取、高血圧などが危険因子とされています。欧米では成人の失明原因の第1位の病気で、日本では比較的少ないと考えられていましたが、高齢者の増加や食生活の欧米化により、日本でも発症率が増加しており、「目の生活習慣病」とも呼ばれています。


種類
加齢黄斑変性には、「滲出型」と「萎縮型」があります。
滲出型
黄斑の下には網膜色素上皮があり、さらにその下に脈絡膜があります。血管の詰まりなどにより網膜の栄養や酸素が不足すると、それを補うために脈絡膜新生血管が作られます。この脈絡膜新生血管はもろくて破れやすく、血液の成分が漏れることがあります。
滲出型では脈絡膜新生血管が発生し、網膜の腫れや出血などを起こすタイプです。
病状の進行が早く急激な視力低下をきたすため、早期に発見、治療を行うことが重要になります。
萎縮型
加齢により網膜に老廃物がたまり、網膜の組織が徐々に萎縮していくタイプです。
病状の進行は緩やかで視力もすぐには悪くなりませんが、時間の経過とともに新生血管が発生し「滲出型」に移行することもあるため定期的な検査が必要です。
- 眼底検査による画像

- OCT検査による画像

正常OCT
加齢黄斑変性のOCT
症状
黄斑にダメージがあると、視力の低下、ものがゆがんで見える、色が変色して見える、視野が欠けるといったさまざまな症状が現れます。
主な症状は下記の通りです。
視力低下
見たいものがはっきり見えなくなります。
変視症
ものがゆがんで見えます。
これは網膜がはれたり網膜下に水がたまったりして黄斑が変形して起こります。
中心暗点
視野の中心が暗くなったり、欠けて見えたりします。
色覚異常
色を感じる錐体細胞は黄斑に密集しています。そのため色の区別がつかなくなったり、色が変色して見えます。
原因
加齢(老化現象)
老化により黄斑部網膜の老廃物を処理する働きが衰え、黄斑部に老廃物が沈着します。
紫外線やブルーライト
紫外線、スマートフォンやパソコン画面、LEDライトから出る青色光(ブルーライト)は角膜と水晶体を通り抜けて網膜に達するため、網膜に大きな負担を与えます。
食生活
日本でも加齢黄斑変性が増えていますが、これは食生活の欧米化も関係していると指摘されています。高脂肪・高糖質食は網膜の炎症を助長する可能性があります。
喫煙
喫煙は目に酸化ストレスを蓄積させ、炎症を引き起こします。
また、血管新生を促進する物質の分泌を促すと考えられています。
遺伝など
遺伝も発症に関係しているとされています。
また、高血圧、糖尿病、肥満などの関与も指摘されています。
治療
滲出型
滲出型は病状の進行が早く急激な視力低下をきたすため、すぐに治療を開始する必要があります。治療の目的としては、脈絡膜新生血管の増殖を抑え退縮させ視力を維持あるいは改善することです。一般的には、新生血管の増殖を抑える抗VEGF薬(血管内皮増殖因子阻害剤)の注射治療が行われます。その他「光線力学的療法」「レーザー光凝固術」などの治療もあります。
萎縮型
残念ながら萎縮型の加齢黄斑変性には現在のところ有効な治療方法はありません。サプリメント(ビタミンC、ビタミンE、亜鉛など)や抗酸化物質の摂取が進行を遅らせる可能性がありますが、視力の回復や完治には至りません。また、滲出型に移行するケースもあるため、定期的に検査を受けることが大切です。
日常生活での注意事項
加齢黄斑変性は加齢が原因で起こる病気のため、誰にでも発症するリスクがあります。喫煙、紫外線、光の刺激、肥満などのリスク要因をできるだけ避けることで、リスクを低下させていきましょう。
- 禁煙
- 紫外線やブルーライトを避ける
-
バランスの取れた食事を摂取する
ルテインなどのカロテノイド類を積極的にとることが加齢黄斑変性の予防に推奨されています。また、ビタミンA、C、Eや、βカロテンなど抗酸化作用のある食材を摂取しましょう。具体的には高脂肪、高糖質食は控え、緑黄色野菜や魚介類を中心とした栄養バランスの良い食生活を心がけましょう。